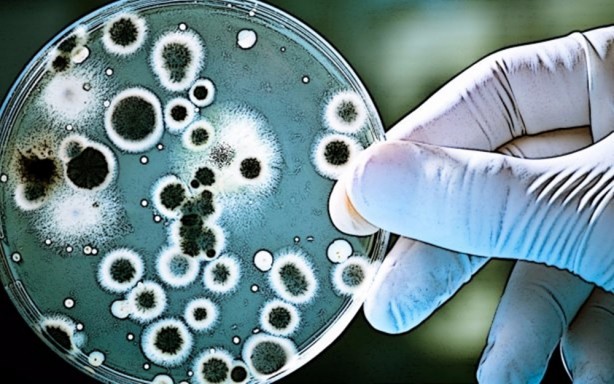
Foto - CIA 15 yıl önce 2015 yılının dünyasını böyle gördü

2015-12-23 15:12:28 CIA 15 yıl önce 2015 yılının dünyasını böyle gördü
ABD’nin Merkezi Haberalma Teşkilatı CIA, 2000 yılında teşkilat dışından bir grup uzmanı biraraya getirdi. Uzmanların görevi yakın geleceğe bakıp, 2015 yılında dünyanın ne durumda olacağını tahmin etmekti. Sonuçta, nantoteknolojiinin yükselişinden petrol şoklarına, demografik değişimden küresel ekonominin durumuna kadar geniş bir yelpazeyi kapsayan 70 sayfalık bir rapor yazıldı. 15 yıl önce bugün hakkında yapılan tahminler ne derece doğruydu? ( Haber: Cnn Türk)